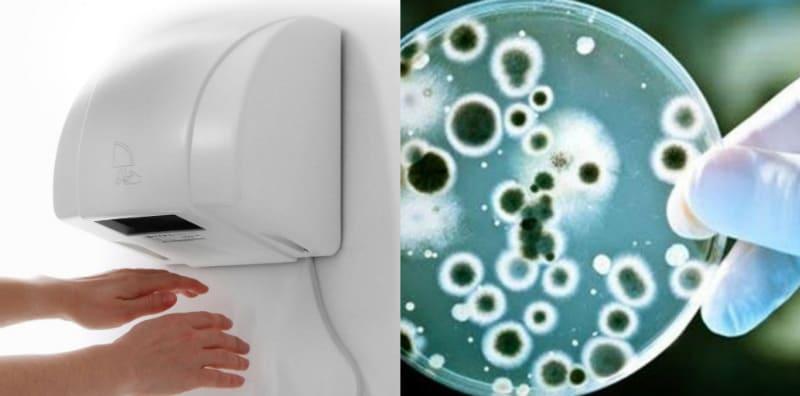
pengering-tangan-sebar-bakteria-tandas

8 Perkara Ini Mungkin Punca Anak Alami Sembelit, Ibu Cuba Semak!
Masalah anak sembelit adalah perkara biasa terutamanya ketika dalam proses latihan tandas sekitar usia 2 hingga 3 tahun. Apakah tanda tanda sembelit yang boleh ibu kenal pasti ya? Jom baca lebih lanjut dalam perkongsian artikel ini. Untuk mendapatkan lebih banyak info tentang Keibubapaan, sila dapatkannya di sini. Masalah anak sembelit Sembelit terjadi apabila anak mempunyai najis dengan tekstur yang […]